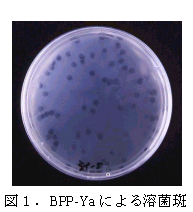

ファージBPP-Yaによるイネ苗立枯細菌病の発病抑制 |
||||||
| [要約] | ||||||
イネ種子を浸種・催芽する際に、イネ苗立枯細菌病菌に対して親和性を持つファージを大量に投与することにより、本病の発病を著しく抑制することができる。 |
||||||
[キーワード]イネ、イネ苗立枯細菌病菌、ファージ、種子消毒、発病抑制 |
||||||
[担当]石川農研・生産環境部・病理昆虫科 [連絡先]電話 076-257-6978 [区分]関東東海北陸農業・北陸・生産環境 [分類]技術・参考 |
||||||
| [背景・ねらい] | ||||||
ファージは宿主病原細菌に対しての選択性が非常に高く、また宿主の溶菌にともない子ファージが放出され、あらたな宿主への感染を繰り返すことから、病害防除への利用は古くから検討されているが、これまでのところ十分な効果が得られた例は少ない。これは、一時的に大量のファージを圃場に投入しても、紫外線等の種々の環境要因の影響により、宿主細菌に吸着する前に多くが不活化するためと考えられる。そこで、イネ苗立枯細菌病菌ファージをあらたに探索し、環境要因を比較的制御しやすい種子消毒作業における利用法について検討する。 |
||||||
[成果の内容・特徴] |
||||||
|
||||||
[成果の活用面・留意点] |
||||||
|
||||||
|
||||||
|
||||||
[その他] |
||||||
研究課題名:遺伝子解析・微生物機能等を活用した病害防除技術の開発 |
||||||
| 目次へ戻る | ||||||